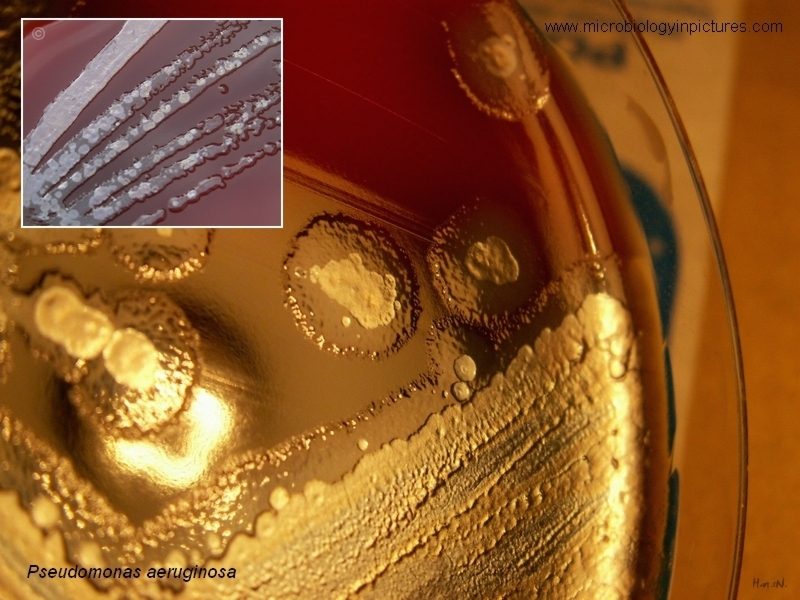

Can bacteria be ill? Yes they can. Practically every bacterium can be infected with a virus = bacteriophage.
Bacteriophages replicate within the bacterium following the injection of their genome into its cytoplasm.
Phages are widely distributed in locations populated by bacterial hosts, such as soil or the intestines of animals.
They have been
used for over 90 years as an alternative to antibiotics in the former Soviet Union and Central Europe, as well as in France. They are
seen as a possible therapy against multi-drug-resistant strains of many bacteria (Wikipedia).
In the picture you can see Pseudomonas aeruginosa colonies on blood agar infected with a lytic phage.
Bacterial cells on the surface
of colonies are lysed and destroyed after immediate replication of the virion. Viral infection is so manifested in the form of opalescent plaques
on the surface of bacterial colonies.

Colonies of Pseudomonas aeruginosa infected with a lytic phage. Cultivation on tryptic soy agar.
More about phage therapy you can find here.